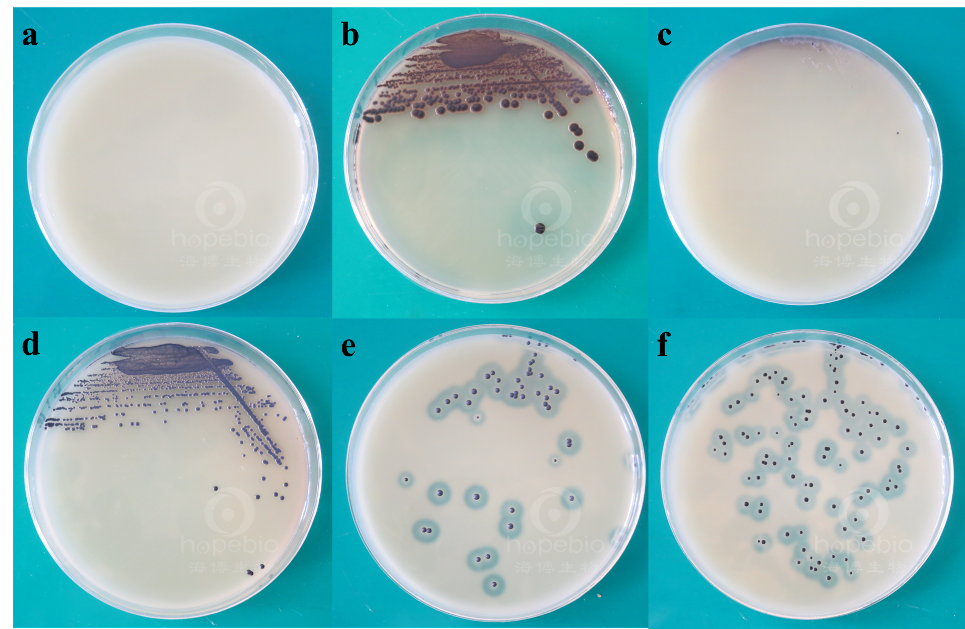
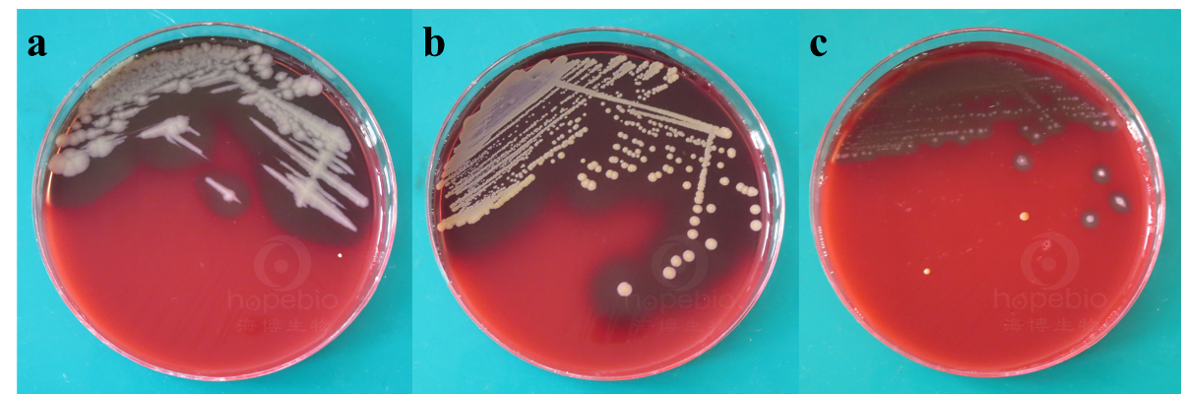
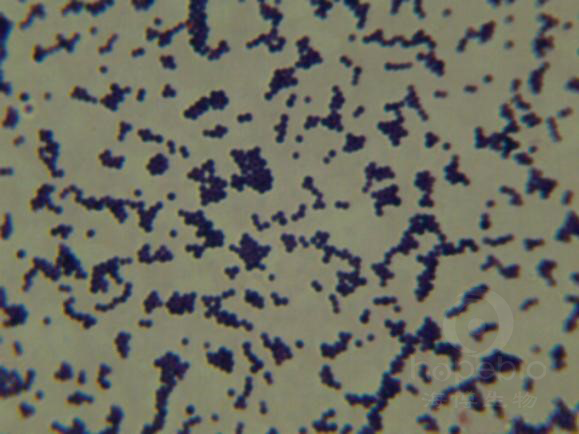

海博微信公众号
海博微信公众号
 海博天猫旗舰店
海博天猫旗舰店


 海博微信公众号
海博微信公众号
 海博天猫旗舰店
海博天猫旗舰店




一、操作步骤及结果判断
1.1样品的处理
称取(或量取)25g(25mL)样品至225mL7.5%氯化钠肉汤中,固体置于无菌均质袋中,液体置于无菌锥形瓶中,均质或振荡混匀。
1.2增菌
将上述匀液置于36℃± 1℃培养18-24h,金黄色葡萄球菌在7.5%氯化钠肉汤中呈浑浊生长。如图1-2a、1-2b所示

图1-2 7.5%氯化钠肉汤结果
a:金黄色葡萄球菌(ATCC25923),b:金黄色葡萄球菌(ATCC6538),c:大肠埃希氏菌,d:空白对照
1.3分离及初步鉴定
将增菌后的培养物,分别划线接种到Baird-Parker平板和血平板,血平板36℃± 1℃培养18-24h,Baird-Parker平板36℃± 1℃培养24-48h。
1.3.1金黄色葡萄球菌在Baird-Parker平板上的菌落特征
表面光滑、凸起、湿润、菌落直径为2mm-3mm,颜色呈灰黑色至黑色,有光泽,常有浅色(非白色)边缘,周围绕以不透明圈(沉淀),其外常有一清晰带,用接种针触及菌落时有黄油样黏稠感,见图1-3-1e、1-3-1f。有时可见到不分解脂肪的菌株,除没有不透明圈和清晰带外,其他外观基本相同。从长期贮存的冷冻或脱水食品中分离的菌落,其灰色常较典型菌落浅些。且外观可能较粗糙,质地较干燥。
图1-3-1 Baird-Parker平板微生物结果
a:大肠埃希氏菌,b:奇异变形杆菌,c:枯草芽孢杆菌,
d:表皮葡萄球菌,e:金黄色葡萄球菌(ATCC25923),f:金黄色葡萄球菌(ATCC6538)
1.3.2金黄色葡萄球菌在血平板上的菌落特征
菌落较大,圆形、光滑凸起、湿润、金黄色(有时为白色),菌落周围可见完全透明溶血圈,见图1-3-2b
图1-3-2血平板微生物结果
a:蜡样芽孢杆菌,b:金黄色葡萄球菌,c:乙型溶血性链球菌
1.4确证鉴定
1.4.1染色镜检
金黄色葡萄球菌为革兰氏阳性球菌,排列成葡萄球状,无芽孢,无荚膜,直径约为0.5-1μm ,革兰氏染色结果如图1-4-1所示。
图1-4-1金黄色葡萄球菌(ATCC6538)革兰氏染色结果
1.4.2血浆凝固酶试验
挑取Baird-Parker平板和血平板上至少5个可疑菌落(小于5个全选),分别接种到5mLBHI和营养琼脂小斜面,36℃± 1℃培养18-24h。
取新鲜配置兔血浆0.5mL,放入小试管中再加入BHI培养物0.2mL-0.3mL,振荡摇匀,置于36℃± 1℃温箱或水浴箱内,每半小时观察一次,观察6h,如果凝固(即将试管倾斜或倒置时,呈现凝块)或凝固体积大于原体积的一半,被判为阳性结果,见图1-4-2。同时以血浆凝固酶试验阳性和阴性葡萄球菌菌株的肉汤培养物作为对照。如结果可疑,挑取斜面上的菌落到5mLBHI,36℃± 1℃培养18-48h,重复试验。

1-4-2血浆凝固酶试验结果
a:空白对照,b:金黄色葡萄球菌(ATCC6538),c:金黄色葡萄球菌(ATCC25923)
二、培养基使用及注意事项
2.1 7.5%氯化钠肉汤培养基
7.5%氯化钠肉汤培养基含较高含量的氯化钠,提供较高的渗透压,抑制大多数非葡萄球菌的生长。
2.2 Baird-Parker琼脂培养基
含有卵磷脂酶的葡萄球菌降解卵黄使菌落产生透明圈,而脂酶作用则产生不透明的沉淀环;凝固酶阳性的葡萄球菌还能还原亚碲酸钾而产生黑色菌落。加入亚碲酸钾卵黄添加剂时,培养基温度温度不应过高,需冷却至50℃左右。
金黄色葡萄球菌的典型菌落状态为有沉淀环和透明圈,但有时可见到不分解脂肪的菌株,无沉淀环和透明圈,从长期贮存的冷冻或脱水食品中分离的菌落其灰色常较典型菌落浅些,且外观可能较粗糙,质地较干燥。所以Baird-Parker平板上生长的菌落大多可视为可疑菌落,需进行进一步鉴定。
2.3 血平板培养基
金黄色葡萄球菌能产生溶血素,使菌落周围产生完全透明溶血环。
注:本文以GB 4789.10-2016食品安全国家标准为依据。
注:本文属海博生物原创,未经允许不得转载。
上一篇:大肠埃希氏菌生化鉴定解析
下一篇:产气荚膜梭菌检验解析及注意事项



